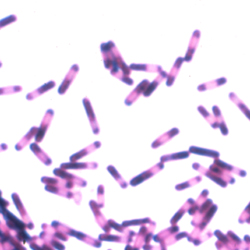

Sir Edward Brotherton Chair of Bacteriology
University of Leeds
National Clinical Director of Antimicrobial Resistance & Infection Prevention and Control
NHS England
Head of Microbiology Research & Development
Leeds Teaching Hospitals NHS Trust
Leeds, England
It has long been known that disruption of the gut microbiome, usually by antibiotics, provides an environment that is conducive to the proliferation of Clostridioides difficile (either already present or acquired during or shortly after antibiotic exposure) and production of exotoxins (toxins A and B) that cause inflammation of the colonic mucosa, which typically manifests as profuse diarrhea. In the last decade, we have started to understand the critical components of the gut microbiome that prevent C. difficile expansion.1,2 With that knowledge comes the potential to block C. difficile proliferation using bacteria-based biotherapeutics.
The FDA views live microorganisms intended to have a therapeutic effect in humans to be a live biotherapeutic product. An Investigational New Drug Application is required, and the drug must be safe, pure, potent, and manufactured consistently according to good manufacturing practices. There is a general principle that all therapeutics should be administered using minimum effective doses, that is, the smallest dose that will produce a desired outcome, to limit the chance of unintended consequences of treatment (adverse events/toxicity). Of course, a margin beyond the absolute minimum effective dose may be justifiable—for example, with antimicrobials—to cover strains with reduced susceptibility. In the context of using a biotherapeutic to alter the dysbiosis that allows C. difficile to proliferate and cause C. difficile infection (CDI) or recurrent CDI (rCDI), the minimal effective dose will encompass both the numbers of microbes administered and the number of different microbes used. Of note, there has been considerable interest in the use of fecal microbiota transplantation (FMT) to treat patients with rCDI, with variable efficacy rates reported.3 In the context of FMT, the minimal effective dose of microorganisms has not been described.
As long ago as 1989, Tvede and Rask-Madsen reported on the use of a mixture of 10 bacterial species administered rectally to achieve CDI resolution in 5 of 5 patients with rCDI.4 A more recent case series of 55 patients managed with the same nonregulated live biotherapeutic was published in 2015; 35 of 55 (64%) had no recurrence of diarrhea within 30 days of treatment.5 However, 1 patient was hospitalized 10 days after bacteriotherapy with appendicitis, fever, and Escherichia coli bacteremia. This is a cautionary example of the potential unintended consequences of bacteriotherapy, including FMT.6 Such safety concerns are partially related to the issue of defining a minimal CDI treatment, and the lack of regulated biotherapeutics for the prevention of CDI recurrence has perpetuated this situation.
Treatment options for rCDI are limited. Bezlotoxumab (Zinplava, Merck), a human monoclonal antibody directed against C. difficile toxin B, administered intravenously, has been the only US-licensed product indicated for the reduction in recurrence of CDI. Recent decisions by the FDA, specifically its approval of fecal microbiota, live-jslm (Rebyota, Ferring/Rebiotix)—known as RBX2660 during clinical trials, a biotherapeutic for the prevention of rCDI7—and fecal microbiota spores, live-brpk (Vowst, Seres Therapeutics), an oral microiome therapeutric for the prevention of rCDI known as SER-109 during clinical trials,8 means that we are now on the cusp of a new era for treatment options, particularly to address the challenge of rCDIs.
Live Biotherapeutic Microbiota Preparations
Rebyota
Rebyota aims to deliver the effectiveness of FMT using a standardized, regulated product for the treatment for rCDI. In the companies’ submission to the FDA, Ferring and Rebiotix noted that their initial pivotal phase 3 clinical trial plan was to conduct 2 independent placebo-controlled, phase 3 trials of about 300 patients each.9 However, recruitment to the first phase 3 clinical trial (2017-01) was slow and made the prospect of successfully concluding a second study very challenging. Instead, Ferring/Rebiotix proposed to use a Bayesian model, based on clinical trial results obtained to date (ie, from a randomized, double-blind, placebo-controlled, phase 3 study [2017-01] and a phase 2b study [2014-01]) to demonstrate a clinically meaningful treatment effect. The FDA’s Center for Biologics Evaluation and Research (CBER) agreed that the results from these 2 similar trials could be analyzed together, and statistical success criteria were established to underpin the analyses of clinical effectiveness of Rebyota. These data formed the basis of the presentation to the FDA’s Vaccines and Related Biological Products Advisory Committee (VRBPAC) in September 2022, and have recently been published.10
Adults who had 1 or more CDI recurrences with a positive stool assay for C. difficile (ie, either for a toxigenic strain or for toxin) and were previously treated with standard-of-care antibiotics were randomly assigned 2:1 to a blinded, single-dose enema of Rebyota (n=180) or placebo (n=87). The primary end point was treatment success, defined as the absence of CDI diarrhea within 8 weeks of study treatment. After applying the Bayesian analysis, the treatment success rate was modeled to be 70.6% with Rebyota versus 57.5% with placebo. The majority (>90%) of successfully treated patients in both study arms at 8 weeks had a sustained response up to 6 months. The size of the improvement in treatment success for Rebyota versus placebo was 13.1% (95% CI, 2.3%-24.0%). This improvement met the posterior probability threshold equivalent to a 1-sided frequentist type 1 error rate less than 0.025, but did not meet the more stringent posterior probability threshold equivalent to a 1-sided frequentist type 1 error rate less than 0.00125.9
The pooled safety data from all patients who were exposed to at least 1 dose of Rebyota in 5 prospective studies included 749 exposed to at least 1 dose of Rebyota and 83 exposed only to placebo. A further 229 patients exposed to open-label Rebyota in Study 2019-01 brought the total prelicensure clinical trial safety database to 978 patients. Rebyota was generally well tolerated. The incidence of treatment-emergent adverse events was higher in Rebyota versus placebo recipients and mostly driven by a higher incidence of mild gastrointestinal events (abdominal pain and diarrhea). No serious treatment-related side effects were reported. Rebyota was evaluated in only a limited number of immunocompromised patients; CBER concluded that the available data were insufficient to determine whether the safety or effectiveness of Rebyota in immunocompromised populations differs from the general population.9
The VRBPAC voted in favor of Rebyota both in terms of its efficacy and safety. The FDA approved its indication to prevent rCDI in adults 18 years of age and older, following antibiotic treatment for rCDI on November 30, 2022.9-10
Vowst
Vowst is a live biotherapeutic comprising an encapsulated mixture of purified Firmicutes spores, obtained from the feces of healthy humans. As such, this biotherapeutic contains considerably fewer different bacteria from those present in Rebyota. As the spores are so resilient, a purification process that includes ethanol treatment is used to reduce the risk that transmissible infectious agents could contaminate Vowst. The pivotal clinical trials of Vowst, which have led to the FDA approval of this oral microbiome therapeutic on April 26, 2023 for the prevention of rCDI,8 are summarized below.
ECOSPOR III (SERES-012; ClinicalTrials.gov Identifier: NCT03183128) was a phase 3, multicenter, randomized, placebo-controlled study that enrolled 182 adults with at least 3 episodes of CDI within the previous 12 months (inclusive of the study entry episode).11 All participants received standard-of-care oral antibiotic treatment (either fidaxomicin [Dificid, Merck] or vancomycin) and were stratified according to age (<65 or =65 years) and CDI antibiotic received before randomization to Vowst (~3×107 spore colony-forming units) or placebo, administered as 4 matching oral capsules once daily over 3 consecutive days. Given that fidaxomicin and vancomycin may persist in feces after cessation of oral administration, 10 ounces of magnesium citrate was administered the night before Vowst receipt to limit inactivation of the bacteria in this therapy. Of note, toxin testing was required at study entry and at suspected recurrence to ensure enrollment of patients with active CDI and accurate assessment of the end point.
Eight weeks after treatment, 88% of Vowst recipients were free from C. difficile recurrence compared with 60% in the placebo group (relative risk of rCDI in Vowst recipients, 0.32; 95% CI, 0.18-0.58; P<0.001). The primary end point, superiority of Vowst versus placebo in reducing risk for CDI recurrence after 8 weeks, was met. This reduction in risk for recurrence was durable at 24 weeks, with the respective proportions of patients without CDI recurrence being 79% versus 53%.12 Also, considering the stratified subgroups, Vowst receipt led to fewer recurrences than placebo in patients at least 65 years of age or younger, and both in those who received fidaxomicin (relative risk, 0.09; 95% CI, 0.01-0.63) or vancomycin (relative risk, 0.41; 95% CI, 0.22-0.79).
Vowst was generally well tolerated with no drug-related serious adverse events.
Stool samples obtained at baseline (within 3 days after completion of fidaxomicin or vancomycin) and at weeks 1, 2, and 8 were analyzed by whole metagenomic sequencing and targeted bile acid analyses to determine whether the spore-forming bacteria in Vowst could compete with C. difficile and/or modulate bile acid profiles leading to a reestablishment of resistance to colonization. The superiority of Vowst compared with placebo at preventing rCDI was associated with clear changes in microbiome composition and concentrations of, in particular, secondary bile acids.11 Of the 182 patients included in the efficacy analysis, 29 were excluded from the metagenomic and metabolomic analyses because of missing specimens or protocol deviations. Engraftment of Vowst bacteria was observed by week 1 and persisted through week 8. Numbers of engrafting Vowst bacterial species were higher among Vowst versus placebo recipients through week 8. Following dosing with Vowst, there were declines in pro-inflammatory Enterobacteriaceae and increases in Firmicutes. Also, greater increases in secondary bile acids from baseline occurred in Vowst recipients at all times through week 8. Secondary bile acids are known to protect against CDI as they inhibit C. difficile spore germination and vegetative growth.13,14 These findings fit with the known key roles of colonic bacteria, including Firmicutes, to promote the synthesis of secondary bile acids.15
Conclusion
With new access to these biotherapeutics for the prevention of rCDI, this will add considerable options to clinicians for the management of this challenging disease. Such regulated biotherapeutics, with clearly defined efficacy and safety parameters, will provide more certainty than is currently associated with FMT. The phase 3 clinical trials of RBX2660 and SER-109 were similar, but there were sufficient differences, including how CDI cases were defined, to add uncertainty to the question of the relative efficacy of the 2 biotherapeutics. It is too early to know the cost-effectiveness of new biotherapeutics for treating CDI, and such data will be awaited with interest, especially given the increasing costs associated with FMT, including the need to screen donors/samples for more potential pathogens.
References
- Berkell M, Mysara M, Xavier BB, et al; ANTICIPATE study group. Microbiota-based markers predictive of development of Clostridioides difficile infection. Nat Commun. 2021;12(1):2241.
- Seekatz AM, Safdar N, Khanna S. The role of the gut microbiome in colonization resistance and recurrent Clostridioides difficile infection. Therap Adv Gastroenterol. Published online 2022 November 18. doi:10.1177/17562848221134396
- Tariq R, Pardi DS, Bartlett MG, et al. Low cure rates in controlled trials of fecal microbiota transplantation for recurrent Clostridium difficile infection: a systematic review and meta-analysis. Clin Infect Dis. 2019;68(8):1351-1358.
- Tvede M, Rask-Madsen J. Bacteriotherapy for chronic relapsing Clostridium difficile diarrhoea in six patients. Lancet. 1989;1(8648):1156-1160.
- Tvede M, Tinggaard M, Helms M. Rectal bacteriotherapy for recurrent Clostridium difficile-associated diarrhoea: results from a case series of 55 patients in Denmark 2000-2012. Clin Microbiol Infect. 2015;21(1):48-53.
- Wilcox MH, McGovern BH, Hecht GA. The efficacy and safety of fecal microbiota transplant for recurrent Clostridium difficile infection: current understanding and gap analysis. Open Forum Infect Dis. 2020;7(5):ofaa114.
- FDA. Rebyota. Accessed February 1, 2023. https://bit.ly/ 3IXPl5D-IDSE
- FDA. FDA approves first orally administered fecal microbiota product for the prevention of recurrence of Clostridioides difficile infection. Accessed September 21, 2023. fda.gov/news-events/press-announcements/fda-approves-first-orally-administered-fecal-microbiota-product-prevention-recurrence-clostridioides.
- FDA. Rebyota BLA clinical review memorandum. Accessed February 7, 2023. https://www.fda.gov/ media/ 164039/ download
- Ferring receives U.S. FDA approval for REBYOTA™ (fecal microbiota, live-jslm) – a novel first-in-class microbiota-based live biotherapeutic. Accessed February 7, 2023. https://bit.ly/ 3JMOcPa-IDSE
- Khanna S, Assi M, Lee C, et al. Efficacy and safety of RBX2660 in PUNCH CD3, a phase III, randomized, double-blind, placebo-controlled trial with a Bayesian primary analysis for the prevention of recurrent Clostridioides difficile infection. Drugs. 2022;82(15):1527-1538.
- Feuerstadt P, Louie TJ, Lashner B, et al. SER-109, an oral microbiome therapy for recurrent Clostridioides difficile infection. N Engl J Med. 2022;386(3):220-229.
- Cohen SH, Louie TJ, Sims M, et al. Extended follow-up of microbiome therapeutic SER-109 through 24 weeks for recurrent Clostridioides difficile infection in a randomized clinical trial. JAMA. 2022;328(20):2062-2064.
- Allegretti JR, Kearney S, Li N, et al. Recurrent Clostridium difficile infection associates with distinct bile acid and microbiome profiles. Aliment Pharmacol Ther. 2016;43:1142-1153.
- Ridlon JM, Harris SC, Bhowmik S, et al. Consequences of bile salt biotransformations by intestinal bacteria. Gut Microbes. 2016;7:22-39.
Dr. Wilcox reported relationships with AiCuris, Almirall, Bayer, Crestone, Da Volterra, Deinove, EnteroBiotix, The European Tissue Symposium, Ferring, GSK, Menarini, Merck, Nestlé, Paion, Paratek, Pfizer, Phico Therapeutics, Qpex Biopharma, Seres, Surface Skins, Summit, Tillotts, Vaxxilon/Idorsia, and Vedanta.
Copyright © 2023 McMahon Publishing, 545 West 45th Street, New York, NY 10036. Printed in the USA. All rights reserved, including the right of reproduction, in whole or in part, in any form.

Download to read this article in PDF document:![]() A New Era for Managing Clostridioides difficile Infection
A New Era for Managing Clostridioides difficile Infection